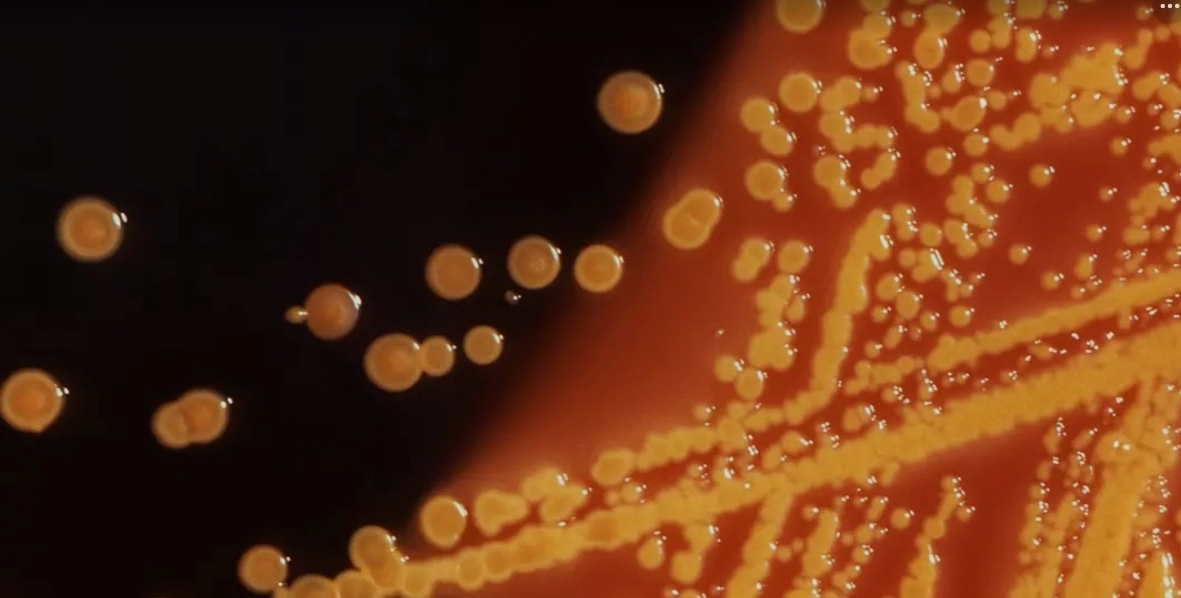
Screenshot_20251222_092121_Google

उत्तराखंड डेली न्यूज:ब्योरो
जापान एडवांस्ड इंस्टीट्यूट ऑफ साइंस ऐंड टेक्नोलॉजी के वैज्ञानिकों ने छिपकली और मेंढक के अंदर मिले बैक्टीरिया पर शोध से पता लगाया है कि उनके ज़रिए आंत के कैंसर का इलाज हो सकता है। रिसर्च ने उम्मीद जगाई है कि भविष्य में कैंसर के इलाज के लिए पारंपरिक कीमोथेरेपी और इम्यूनोथेरेपी के अलावा ज़्यादा सुरक्षित विकल्प उपलब्ध हो सकते हैं।




